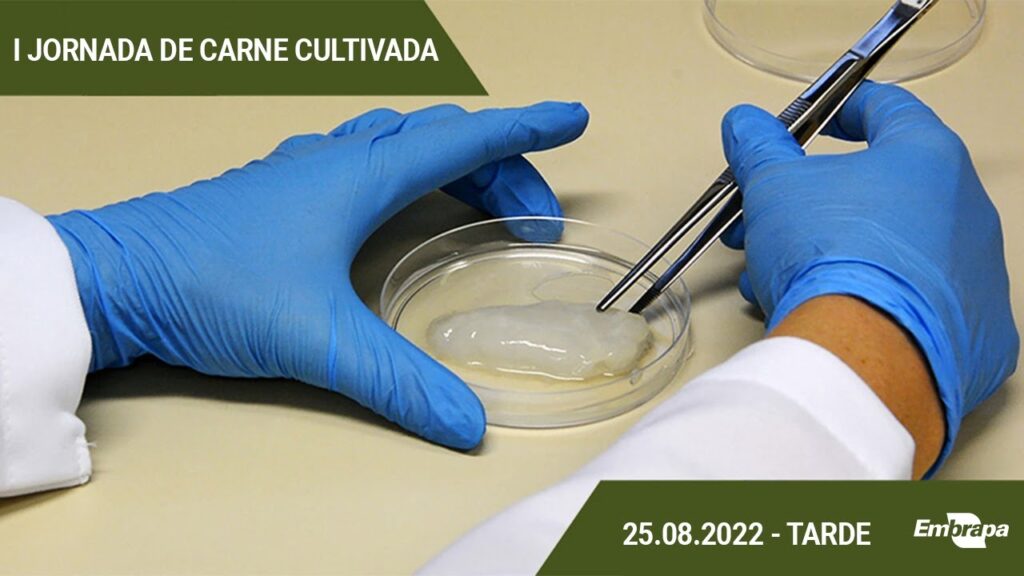
i jornada de carne cultivada embrapa suinos e aves 25 de agosto tarde

Flórida proíbe carne de laboratório | Impacto na pecuária
O Estado da Flórida proíbe a venda e produção de carne cultivada em laboratório A crescente demanda por alternativas sustentáveis na produção de alimentos tem levado ao desenvolvimento de carne cultivada em laboratório. No entanto, o estado americano da Flórida tomou uma decisão controversa ao proibir a venda e produção desse tipo de carne em […]
Flórida proíbe carne de laboratório | Impacto na pecuária Read More »